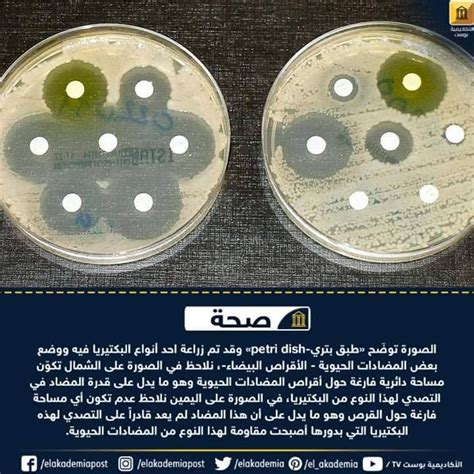

جدول المحتويات
عينات المضادات الحيوية المختلفة وتأثيرها على نمو البكتيريا
وتجدر الإشارة إلى أنه بسبب ضعف جهاز المناعة أو عيب آخر، قد يعاني الشخص من بعض التغيرات الفسيولوجية ويصاب بمرض ما، فقد يلجأ الكثير من الأشخاص إلى المضادات الحيوية التي يمكن أن تخفف الألم لفترة محدودة من الزمن، مثل المسكنات، أكامول وكيتامول يستخدمهما كثير من الناس للمساعدة في مكافحة الالتهاب أو الألم المستمر.
عينات مختلفة من المضاد الحيوي وتأثيراته على نمو البكتيريا؟
يمكن أن يؤدي الاستخدام المتكرر أو غير السليم للمضادات الحيوية إلى تعزيز المقاومة المضادة، بحيث لا تعود هذه المضادات الحيوية قادرة على التعلم ضد البكتيريا. تبلغ نسبة الاستخدام غير الضروري لهذه المضادات الحيوية حوالي الثلث أو النصف، وفقًا لمركز السيطرة على الأمراض.